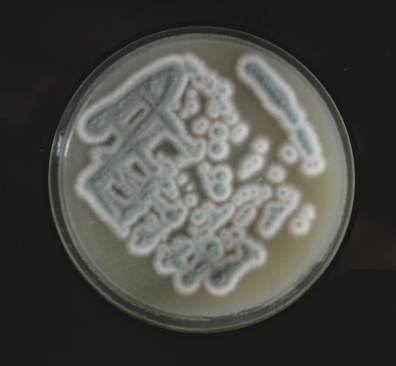

텅스텐은 다양한 분야에 사용되는 아주 중요한 금속이야. 하지만 텅스텐을 캐내는 과정에서 발생하는 여러 문제도 극복해야 해. 다행인 건 이런 문제를 해결할 수 있는 다양한 방법이 연구되고 있다는 거야.
물도 아끼고, 환경 오염도 줄이자
텅스텐은 회중석, 흑중석 등 다양한 광물에 녹아 있기 때문에 가공하는 과정을 거쳐야 순수한 텅스텐을 얻을 수 있어요. 텅스텐은 주로 ‘습식 제련’ 방법을 통해 얻을 수 있습니다. 습식 제련은 광석에 물이나 수용액을 반응시켜 금속을 얻는 방법이에요. 용액에 금속을 녹이고 전기분해 등을 이용해 순수한 금속을 얻을 수 있지요.
그런데 이러한 습식 제련 과정에서는 물이 많이 사용된다는 문제점이 있습니다. 텅스텐 광석 1t을 처리할 때 불순물을 씻어내기 위해 평균적으로 물 4~7t이 이용됩니다. 이 양은 성인 1명이 한 달 동안 사용하는 물의 양과 맞먹어요. 그렇기 때문에 많은 나라에서는 텅스텐을 얻을 때 물을 재활용하는 방법을 연구하고 있어요. 예를 들어, 상동광산에서는 공정에 사용된 물을 순환 시스템으로 처리해 대부분을 다시 공정에 쓰고 있지요.


또, 텅스텐은 재활용률이 높은 금속 중 하나입니다. 금속을 자르는 기계에 사용되는 텅스텐은 80% 이상을 재활용할 수 있습니다. 그러나 텅스텐은 안정적인 금속이라 그대로 녹여 사용하기는 어려워요. 그래서 암모니아를 이용해 텅스텐을 물에 녹는 화합물로 바꾼 뒤, 불순물을 없애고 다시 순수한 텅스텐으로 만듭니다.
그런데 이 과정에서 사용되는 암모니아가 문제가 될 수 있어요. 광산에서 사용된 뒤 제대로 처리되지 않은 암모니아가 강으로 흐르면 플랑크톤이 갑자기 많아져 수질오염이 발생할 수 있어요. 또, 플랑크톤이 물 안의 산소를 많이 사용하면서 강에 사는 물고기 수가 줄고 결국 생태계 균형이 망가질 수 있지요. 그래서 과학자들은 암모니아를 대체할 수 있는 방안을 연구하고 있습니다.
포항공과대학교 화학공학과 등 공동 연구팀은 반도체 폐기물에서 곰팡이를 이용해 텅스텐을 얻는 방법을 국제 학술지 ‘ACS 서스테이너블 케미스트리 앤 엔지니어링’에 2024년 7월 밝혔습니다. 연구팀은 곰팡이 ‘페니실리움 심플리시움’이 성장하면서 내뿜는 산에 주목했어요. 산으로 반도체 폐기물 안의 텅스텐을 이온으로 녹이고, 이온을 산과 결합시키자 텅스텐을 얻을 수 있었지요. 포항공과대학교 화학공학과 한지훈 교수는 “환경 오염도 막고 자원도 재활용할 수 있는 방법”이라고 설명했습니다.